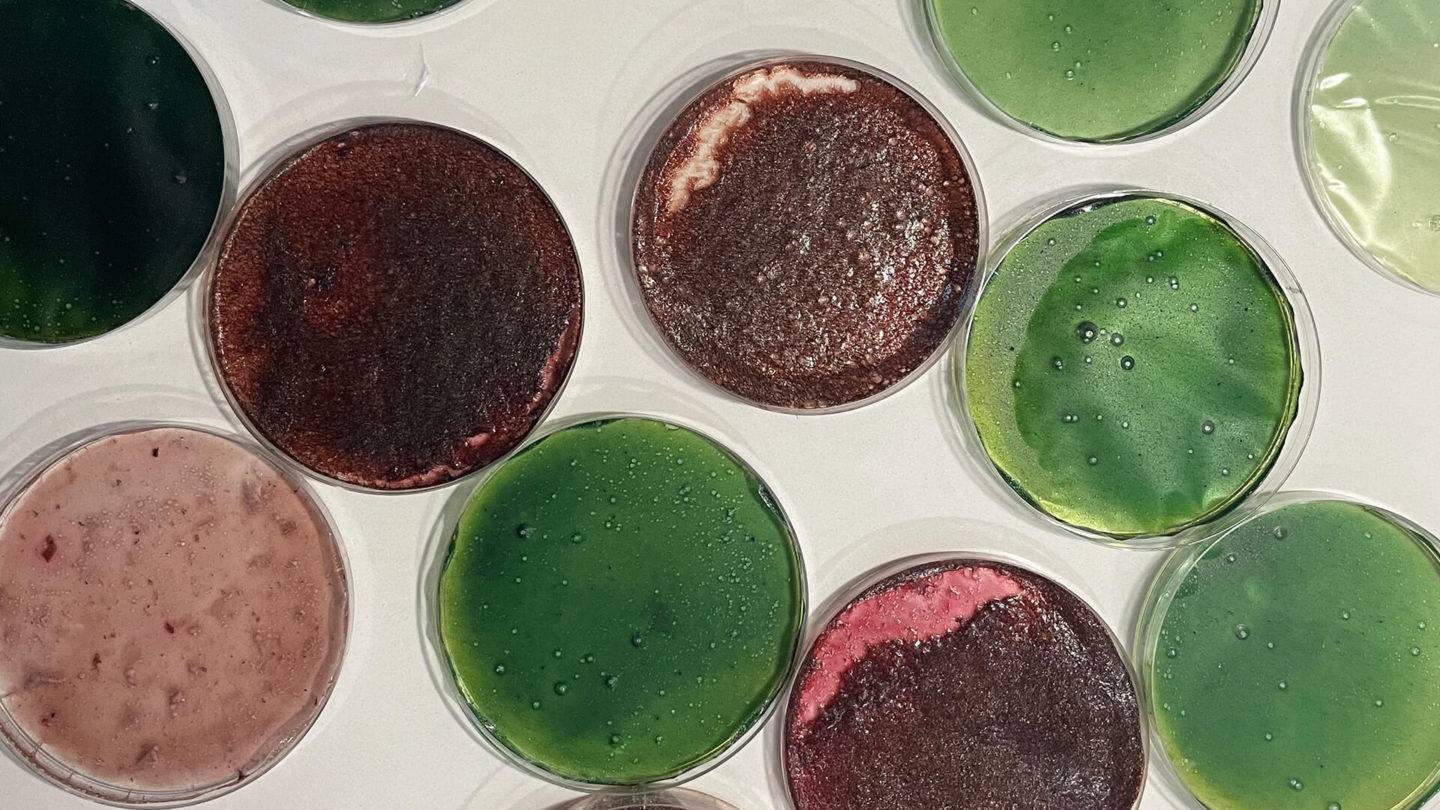
Biodegradable ECG samples

What can we learn from nature to create healthier materials?
For our 6th annual collaboration with the Royal College of Art, PriestmanGoode challenged students from the MA Textiles course to create new materials that are better for our health and better for the planet.
Health has been the major focus across the world for the past two years. Even before the pandemic, studies have found that we spend 90% of our time indoors. The enforced isolation that many people faced during this time has led to a greater appreciation of the benefits of being outdoors and the power of nature. It has also become more apparent that the indoor environments we inhabit can have a detrimental impact on our health.
Therefore students were encouraged to consider how new materials could have an impact on these spaces? The wide-ranging investigations and outcomes consider functionality and aesthetics, as well as circular design principles.
The students’ work is being unveiled during London Design Week 2022 with a window exhibition at PriestmanGoode’s studio at 150 Great Portland Street, London. The annual programme is part of the company’s commitment to supporting creative education, with the winning student selected for a paid internship with PriestmanGoode.
Details of the winner, highly commended entries and runners up can be found below.

Wellbeing boost from salt and rust
The narrative of McDonnell’s project has a strong connection to her Norfolk roots and involved an unlikely mix of materials, rust, seaweed, and salt – all brought together to create more sustainable and user-healthy processes within the design. The project included experimentation with natural dyeing using metals, investigations with the material SeaCell™ and the process of adhering salt to textiles. Each focused on the creation of materials with benefits for the user and the environment, and were contextualised through the lens of salt therapy. SeaCell is a textile made from seaweed. The fibre is full of nutrients, is antibacterial, and rich in oxygen. Salt therapy is a spa method that involves breathing in air with tiny salt particles. It has been proven to ease a variety of conditions, improve the respiratory system, and improve mental wellbeing. The conclusions of the project led towards the idea of introducing oxygen-rich salt therapy into commercial spaces by interlacing salt into SeaCell woven textiles and existing air filtration systems.







Eco-friendly adhesive from okra – inspired by mussels
Inspired by biomimicry, Chen’s project considers natural alternatives for adhesives and their application in automotive interiors. Starting with a review of past innovation in adhesives, and experiments with okra-based alternatives, the research was also inspired by mussels, and how the mussel byssus filaments and adhesive proteins could be applied to weaving and bonding processes. Using the theory of bionics – or biologically inspired engineering – Chen conducted a series of adhesion experiments with okra, inspired by the potential of natural composites to offer more sustainable outcomes. Through textile design, this work could provide new ideas and avenues for eco-friendly adhesives, exploring their application in numerous potential settings.






Wax and honey bring sensory calm
Dolbniak presents an empathic approach to dealing with sensory overload on public transport by creating a nature-inspired solution to ‘fidgets’. Initial material sampling including wax and honey to find a sustainable and circular substitute for the non-biodegradable silicone typically used in these products. The alternative bio foams and plastics explored in the project have a range of stimulating textures. Senses such as touch, smell, and sight are triggered by natural additions to their surface including cork, groats (hulled kernels of various grains) and aromatic oils – helping to ensure it remains 100% biodegradable. The tube shape of the design is both comforting and serves to distract from unwanted external stimuli in the surroundings. A sensory guide was created by Dolbniak to support effective communication and contextualisation of her design decisions to a sensory-sensitive user. For example, how does it feel to have different textures in the same colour?






California-inspired vegan tiles
Wozencroft’s research looked at the concept of sustainable materials, influenced by the latest social trends in wellness culture and well-being, as found in Los Angeles, California. The outcome, a multi-purpose tile product, is formed of 100% vegan materials that capture the essence of a Californian vegan lifestyle. The use of organic natural pigments from Japanese knotweed bark and spirulina generate a variety of colour tones that are used to create modern geometric patterns, as well as highlight the uniqueness and craftsmanship in each tile piece. The tile design is suitable to be used in various backgrounds and surfaces such as full wall coverings or as statement art.




Biodegradable ECG pads from seaweed
The issue of environmental pollution from disposable medical supplies has become more prominent since the advent of COVID-19. The new prototype electrocardiogram “ECG” pads developed in Yang’s project follow the same principle of existing pads, but with an innovative approach to the materials used. In the prototype, the parts that attach to the body use alginate sodium film (formed from 70–80% seaweed) and graphene fibre. The materials are dyed with natural pigments and they dissolve in water. Whereas traditional ECG pads take decades to decompose, it only takes a few minutes for the new prototype pads to go back to nature. This new thinking on materials has the potential to revolutionise traditional disposable medical supplies, as well as any product that uses disposable conductor films or disposable conductive products.

From bones to bio seating foams
Sargent envisaged a future that includes interactivity and engagement with the world of materials by designing for the community and for spaces that encourage socialisation. Therefore her project considers the development of a sustainable and biodegradable foam, for use in public space interiors, and in particular seating design. Experiments achieved various levels of flexibility from the mono-material samples, created to enable future recycling and regeneration. All colours used were derived from natural ingredients and, when combined with the elements used in the bio-foam they remain saturated, as Sargent found the chemical elements readily bonded together. The design of the seating follows a skeletal formation helping the user achieve a good posture but also correlating with the bio foam materials which are also derived from bones.




Biomaterials using seaweed for food packaging
Can we combine household waste and natural resources to make a more durable and sustainable material? That was the question asked by Kirkpatrick in her project where she explored the properties of various seaweed species in their many forms and the qualities they hold. She aimed to advance our relationship with the materials we use and discover ways that we can be beneficial to our planet rather than harmful. Notable features of seaweed are its strength and waterproofing properties and therefore the project assessed how these can be transferred into a material that could potentially replace many single use plastic items. Taking the initial ideas further, the addition of household waste paper meant that the material could have more structure and has the potential to replace traditional paper packaging used in the food industry, as one example.





















